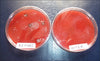
Gift Card
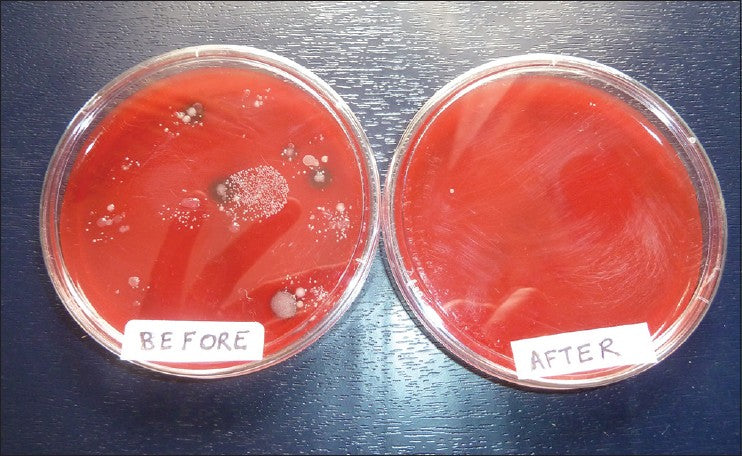

PRODUCT INFORMATION
Gift Card
OUR CUSTOMERS SAY
Keeping You and Your Phone Protected

Protect, Clean and Sanitize
The world's only phone and tablet cases that protect your mobile devices from damage whilst cleaning the screen of greasy fingermarks and neutralizes germs, bacteria and viruses.




Kills Cold, Flu & Corona Viruses
Say goodbye to illness-causing bacteria on your devices with NueVue cases.
Our solution not only safeguards your phone but also sanitizes it while in the case.
You'll love the sleek design that fits comfortably in your pocket or bag, without any unnecessary bulk.
In just a few short minutes, your phone will be free and clear of hazardous bacteria that can make you and others ill.




Dirty Screens Cause Eyestrain, Headaches and Migraines
NueVue cases are great at protecting you and your internal health, and they also take care of your eye health.
Each case has more than 7 million microfibres that removes germs and swipes away your greasy fingerprints with every slide. This not only makes your screen look 10x better, but reduces the strain on your eyes which can cause tiredness and headaches.
Simply put in your device for a clean screen with every slide.




Works Around The Clock
NueVue cases lining is infused the world's most advanced antimicrobial technology to eliminate 99.99% of bacteria, germs and viruses that can live and breed on your phone or Pad for days.
There's no transfer or dilution of the additive so it works at 100% full strength for the life of the case.
Keeping you safe from pathogens.
Every minute of every day, forever.